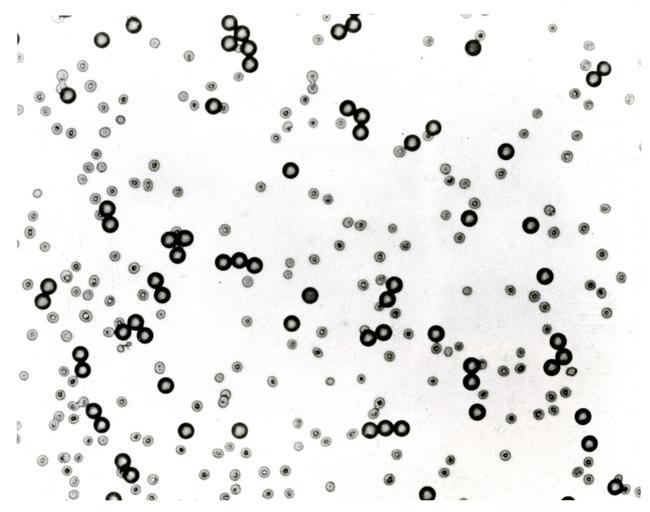

MAKE A MEME
View Large Image
| View Original: | SpaceBeadsSRM_030.jpg (5843x4599) | |||
| Download: | Original | Medium | Small | Thumb |
| Courtesy of: | commons.wikimedia.org | More Like This | ||
| Keywords: SpaceBeadsSRM 030.jpg A small area of a microscope slide shows human red blood cells along with the 10-micrometer spheres dark circles that were made in space NBS standard reference material SRM 1960 10-Micrometer Polystyrene Spheres is an inmportant tool for calibrating instruments to measure small particles such as blood cells National Institute of Standards and Technology National Institute of Standards and Technology PD-USGov-NIST PD-USGov National Bureau of Standards National Institute of Standards and Technology Space Beads | ||||